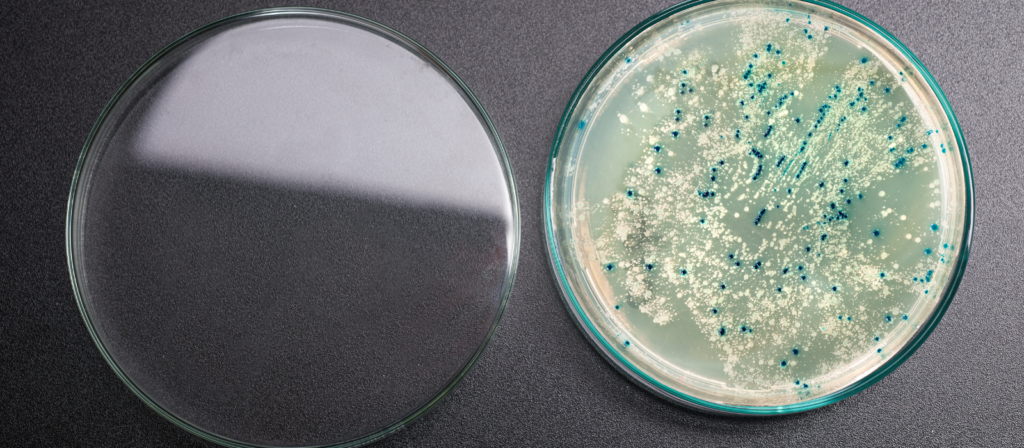

Contador de Colônias: A Ferramenta Essencial para Precisão em Microbiologia
Um contador de colônias é muito mais do que um instrumento para laboratório — é a ferramenta fundamental que determina a confiabilidade de suas análises microbiológicas. Seja você trabalhando em alimentos, farmacêutica, análises clínicas ou pesquisa, a precisão na contagem de colônias é não-negociável para conformidade regulatória (ISO 7218, Farmacopeia Brasileira, ANVISA) e para garantir resultados que seus clientes e auditores possam confiar. O problema? Contadores manuais dependem 100% da habilidade do operador, iluminação e consistência — fatores que introduzem variabilidade humana de 3–10% em cada análise.
Um contador de colônias bem escolhido — durável, com ampliação adequada e suporte técnico — reduz esse erro para <2% e oferece rastreabilidade completa. Neste guia, você vai entender exatamente como escolher o melhor contador de colônias para sua realidade, evitar os erros mais comuns que comprometem seus resultados, e implementar um procedimento robusto que passa em qualquer auditoria.
Laboratórios em indústrias alimentícias, farmacêuticas, análises clínicas e pesquisa enfrentam um dilema universal: contar colônias manualmente = risco humano. Um erro de contagem — uma colônia que passou despercebida ou foi contada duas vezes — pode resultar em resultados imprecisos que comprometem diagnósticos, aprovas inadequadas ou rejeições desnecessárias.
Para garantir conformidade com padrões nacionais e internacionais (ISO 7218, Farmacopeia Brasileira, ANVISA), a precisão não é negociável. E aqui está o problema: contadores manuais dependem 100% da habilidade do operador, fadiga visual, iluminação e consistência — fatores que nenhum laboratorista controla perfeitamente.
O resultado? Retrabalho, perda de credibilidade, e pior: risco de não conformidade caso uma auditoria detecte inconsistências.
3 RAZÕES PARA ADOTAR UM CONTADOR DE COLÔNIAS
Um operador manual leva 15–30 minutos para contar uma placa densamente povoada com precisão aceitável
Margem de erro humano: 3–10% em contagens regulares
Um resultado impreciso que passa desapercebido = retrabalho, reputação danificada, possível ação regulatória
Auditoria regulatória encontrando inconsistências = observações não conformes, perda de acreditação
Um contador de colônias bem calibrado e mantido elimina variabilidade e oferece rastreabilidade completa de cada análise. Não é comodidade. É confiabilidade.

🔍 POR QUE SPLABOR?
Quando você escolhe um contador de colônias Splabor, você não está apenas comprando um equipamento. Está escolhendo:
✅ ONIP Certificada
Fornecedores certificados para setores de alta exigência (petróleo, alimentos, farmacêutica). Auditados regularmente, nossos equipamentos atendem aos padrões mais rigorosos — o mesmo que ANVISA, ISO, Farmacopeia Brasileira exigem.
✅ 25+ Anos de Confiabilidade
Desde 1998 garantindo precisão em laboratórios brasileiros. Prêmio Máster Cana 2003 em Assistência Técnica. Centenas de laboratórios confiam em nós há uma década ou mais.
✅ Suporte Técnico em Vídeo
Não fica sozinho. Atendimento técnico remoto com vídeo, orientação para calibração e boas práticas conforme normas técnicas.
✅ Modelo SP-CC/AAA 0–9999
Best-seller para laboratórios de todas as escalas:
Contagem até 9.999 colônias (cobre >99% das aplicações)
Ampliação 3–6x reduz fadiga visual 30–40%
Durabilidade comprovada: 10+ anos
Simplicidade operacional + precisão real

Resumo: Um contador de colônias Splabor dura 2–3x mais, requer menos manutenção e oferece operação otimizada. Em 10 anos, você economiza em substituições e retrabalho.
TRÊS RAZÕES PARA AGIR AGORA
1️⃣ Conformidade Regulatória
ANVISA, Farmacopeia Brasileira, ISO 7218 — todas as normas exigem rastreabilidade e consistência na contagem. Um contador confiável documentado garante aprovação em auditorias.
2️⃣ Redução de Retrabalho
Cada análise imprecisa = retrabalho custoso ou perda de reputação. Um contador Splabor reduz variabilidade humana significativamente.
3️⃣ Durabilidade = Operação Confiável
Contadores genéricos deterioram em 3–5 anos. Splabor dura 10+. Uma ferramenta que acompanha seu crescimento.

PERGUNTAS FREQUENTES (RÁPIDAS)
P1: Como escolher o intervalo correto de contagem?
R: 30–300 colônias = resultado confiável (erro <2%).
Se tem <30: use diluição menor
Se tem >300: use diluição maior
ISO 7218 e Farmacopeia Brasileira recomendam este intervalo para reprodutibilidade.
P2: Quais são os erros mais comuns?
R:Fadiga visual (40% dos erros) — descanso 5 min a cada 10–15 placas
Iluminação inadequada — base translúcida + ambiente bem iluminado
Contagem dupla — marque conforme conta
SOP inconsistente — documentação + treinamento
Implementar estas práticas reduz erro de 5–10% para <2%.
P3: Como validar precisão?
R: Teste simples:
Escolha 3 placas padrão (30–100 colônias)
Mesmo operador conta 3x cada placa
Variabilidade <5% = preciso
Faça mensalmente. Validação documentada = aprovação em auditorias.
P4: Como documentar para conformidade?
R: Registre obrigatoriamente:
Data/hora, amostra, diluição, operador
Colônias contadas + resultado final em UFC/mL
Incubação (dias, temperatura)
Exemplo: 25/05/2026 | Água-01 | 10^-5 | 85 colônias | João Silva | 8,5×10^6 UFC/mL
Documentação completa = 90%+ aprovação em auditorias.
PRÓXIMOS PASSOS
Você já identificou que precisão e rastreabilidade são críticas. Agora é hora de agir.
☎️ OPÇÃO 1: Consultoria Técnica Rápida
Qual modelo se encaixa no seu volume e orçamento?
📞 (18) 3908-7077 | 💬 (18) 99608-9091 | 📧 cotacao@splabor.com.br
CONCLUSÃO
Um contador de colônias confiável é infraestrutura fundamental para qualquer laboratório competitivo, seguro e regulatoriamente compliant.
A cada dia que você adia, corre risco de:
❌ Análise imprecisa afetando diagnósticos
❌ Falha em auditoria regulatória
❌ Perda de credibilidade
❌ Retrabalho custoso
Splabor oferece: contador de colônia manual 0–9999 com ampliação 3–6x, 10+ anos de durabilidade, precisão certificada, suporte técnico.
Escolher qualidade agora = operação confiável nos próximos 10 anos.
📌 DÚVIDAS? ESTAMOS ON-LINE

A Splabor é uma empresa líder no ramo de fabricação de equipamentos para laboratório, especializada em oferecer uma ampla variedade de equipamentos para laboratórios, materiais e produtos para laboratório de alta qualidade.